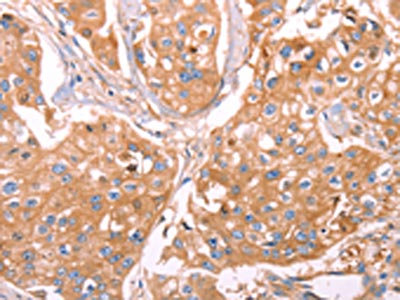

GC Antibody
-
中文名稱:GC兔多克隆抗體
-
貨號:CSB-PA964049
-
規(guī)格:¥1100
-
圖片:
-
The image on the left is immunohistochemistry of paraffin-embedded Human liver cancer tissue using CSB-PA964049(GC Antibody) at dilution 1/40, on the right is treated with fusion protein. (Original magnification: ×200)
-
The image on the left is immunohistochemistry of paraffin-embedded Human breast cancer tissue using CSB-PA964049(GC Antibody) at dilution 1/40, on the right is treated with fusion protein. (Original magnification: ×200)
-
Gel: 10%SDS-PAGE, Lysate: 50 μg, Lane 1-2: Human fetal liver tissue, A549 cells, Primary antibody: CSB-PA964049(GC Antibody) at dilution 1/500, Secondary antibody: Goat anti rabbit IgG at 1/8000 dilution, Exposure time: 20 seconds
-
-
其他:
產(chǎn)品詳情
-
Uniprot No.:
-
基因名:GC
-
別名:DBP antibody; DBP/GC antibody; GC antibody; Gc globulin antibody; Gc-globulin antibody; GRD3 antibody; Group specific component antibody; Group specific component vitamin D binding protein antibody; Group-specific component antibody; hDBP antibody; VDB antibody; VDBG antibody; VDBP antibody; Vitamin D binding alpha globulin antibody; Vitamin D-binding protein antibody; VTDB_HUMAN antibody
-
宿主:Rabbit
-
反應種屬:Human
-
免疫原:Fusion protein of Human GC
-
免疫原種屬:Homo sapiens (Human)
-
標記方式:Non-conjugated
-
抗體亞型:IgG
-
純化方式:Antigen affinity purification
-
濃度:It differs from different batches. Please contact us to confirm it.
-
保存緩沖液:-20°C, pH7.4 PBS, 0.05% NaN3, 40% Glycerol
-
產(chǎn)品提供形式:Liquid
-
應用范圍:ELISA,WB,IHC
-
推薦稀釋比:
Application Recommended Dilution ELISA 1:2000-1:5000 WB 1:500-1:2000 IHC 1:50-1:200 -
Protocols:
-
儲存條件:Upon receipt, store at -20°C or -80°C. Avoid repeated freeze.
-
貨期:Basically, we can dispatch the products out in 1-3 working days after receiving your orders. Delivery time maybe differs from different purchasing way or location, please kindly consult your local distributors for specific delivery time.
-
用途:For Research Use Only. Not for use in diagnostic or therapeutic procedures.
相關產(chǎn)品
靶點詳情
-
功能:Involved in vitamin D transport and storage, scavenging of extracellular G-actin, enhancement of the chemotactic activity of C5 alpha for neutrophils in inflammation and macrophage activation.
-
基因功能參考文獻:
- VDBP in the cervicovaginal fluid (CVF) independently predicts intra-amniotic infection and imminent preterm delivery in women with PTL, whereas in women with preterm premature rupture of membranes, an elevated VDBP level in CVF is not associated with increased risks of these two outcome variables. PMID: 29879190
- SNPs of the VDR and GC genes are associated with vitamin D deficiency in postmenopausal Mexican women. PMID: 30150596
- GC rs7041 genotype modified the effects of pregnancy on maternal and placental vitamin D metabolism. PMID: 29196501
- Urinary VDBP correlated with proteinuria and renal SLE disease activity index, and predicted the development of proteinuria in lupus nephritis. PMID: 29958502
- Findings implied that VDBP rs7041-G and rs3733359-T variants may contribute to increased susceptibility to HCV infection in a high-risk Chinese population. PMID: 30218750
- Polymorphisms of VDBP rs4588 and rs2282679 may play a potentially important role in epilepsy susceptibility. PMID: 29993274
- The study findings suggested a possible clinical application of uVDPB as an early and a good marker for the detection of early renal disease in type 2 diabetes mellitus Saudi patients. PMID: 29850609
- GC gene variant has no effect on 25-hydroxyvitamin D levels. PMID: 28892641
- genetic association study in population in north India: Data suggest (1) GT allele of VDBP SNP rs7041, (2) VDBP allelic combination (GC1F/1F: T allele rs4588; C allele rs7041), and (3) GA allele of CYP2R1 SNP rs2060793 are associated with vitamin D deficiency in women with PCOS (polycystic ovarian syndrome) in population studied. (VDBP = vitamin D-binding protein; CYP2R1 = cytochrome P450 family 2 subfamily R member 1) PMID: 28008453
- The A allele of VDBP gene polymorphism might be a potential risk factor for progression of chronic urticarial. PMID: 29165650
- The present study indicates an association between VDR and vitamin D binding protein Single Nucleotide Polymorphisms and Type 1 Diabetes Mellitus among Turkish subjects. PMID: 29506625
- Survival analyses showed that the vitamin D binding protein C allele was correlated with poor disease-free survival (DFS). PMID: 29409465
- These findings showed that racial/ethnic variations in bioavailable vitamin D do not explain the lack of association between 25-hydroxyvitamin D and multiple sclerosis in blacks and Hispanics; and they further challenge the biological plausibility of vitamin D deficiency as causal for MS. PMID: 29414925
- We observed associations between VDR, GC, and CYP27B1 variants and maternal 25-hydroxyvitamin D concentration. Our results provide additional support for a possible role of genetic variation in vitamin D metabolism genes on vitamin D status during pregnancy. PMID: 29175129
- Data show that vitamin D-binding protein (DBP) is elevated in the CSF of temporal lobe epilepsy patients. PMID: 19109932
- In a Turkish Parkinson disease cohort, rs7041 of GC was associated with the PD risk. The homozygous major allele carriers for rs2282679, rs3755967 and rs2298850 of GC gene in PD patients with slower progression had significantly higher levels of serum 25OHD. This is the first study demonstrating GC gene as a risk factor for PD. PMID: 27282160
- Vitamin D levels are associated with severity of liver fibrosis in chronic hepatitis C genotype 1 patients. Although the rs7041 and rs4588 GC polymorphisms are strong predictors of vitamin D levels, they do not play a direct role in liver fibrosis. PMID: 28809744
- Vitamin D binding protein polymorphisms were frequently associated to fibrosis grade in chronic hepatitis C suggesting that they could be used as disease evaluation markers to understand the mechanisms underlying the virus-host interaction. PMID: 29465575
- Findings indicate that Gc globulin (GC) rs16847024, retinoid X receptor gamma (RXRG) rs17429130 and retinoid X receptor alpha (RXRA) rs4917356 were candidate susceptibility markers for gestational diabetes mellitus (GDM) in Chinese females. PMID: 27636996
- Increased circulating levels of vitamin D binding protein in multiple sclerosis patients. PMID: 25590278
- Results show that APOE, DBP and AGT identified were associated with survival outcomes in metastatic colorectal cancer patients treated with chemotherapy and bevacizumab PMID: 25428203
- results provide a direct evidence of cross-talk among the structural domains of DBP PMID: 18035050
- DBP strictly inhibited the production of 1alpha,25-dihydroxyvitamin D3 and 25-hydroxyvitamin D3-induced T cell responses. PMID: 25230725
- 25(OH)D2 half-life was shorter than 25(OH)D3 half-life, and half-lives were affected by DBP concentration and genotype PMID: 24885631
- The interaction between vitamin D status, as measured by circulating 25(OH)D and DBP rs2282679 genotypes, modified the association between 25(OH)D and BMD and bone markers PMID: 25890042
- Data suggest that, while low circulating levels of DBP contribute to low circulating levels of 25-hydroxyvitamin D in patients with PHPT (primary hyperparathyroidism), low DBP alone is not responsible for the hypovitaminosis D observed in these patients; vitamin D metabolism is likely to be generally disturbed in PHPT. [EDITORIAL] PMID: 27858283
- the purpose of this investigation was to assess the relative degree of O-linked trisaccharide glycosylation of DBP in breast, colorectal, pancreatic, and prostate cancer patients compared with healthy individuals. PMID: 19642159
- Comparison of Two ELISA Methods and Mass Spectrometry for Measurement of Vitamin D-Binding Protein: Implications for the Assessment of Bioavailable Vitamin D Concentrations Across Genotypes. PMID: 27250744
- Single-nucleotide polymorphisms in the vitamin D binding protein genewere independently associated with lower 25-hydroxy-vitamin Dand higher 24,25-dihydroxy-vitamin D. PMID: 27313313
- genetic association studies in a population in Brazil: Data suggest that SNPs in RXRG (rs2134095) and GC (rs7041) are associated with low-density lipoprotein cholesterol levels and hypercholesterolemia in the population studied; there was no apparent association with an SNP in VDR (rs2228570). (RXRG = retinoid X receptor gamma; GC = vitamin D-binding protein; VDR = vitamin D receptor) PMID: 27721113
- The study strongly suggests that there might have an association of vitamin D, and vitamin D-binding protein gene (codon 416 & 420) polymorphisms with the occurrence of type 2 diabetes mellitus PMID: 28888576
- Low serum vitamin D-binding protein concentrations are associated with type 1 diabetes. PMID: 27103201
- rs7041 polymorphism of Vitamin D Binding Protein does not affect platelet reactivity or the rate of high-residual platelet reactivity among patients receiving dual antiplatelet therapy with clopidogrel or ticagrelor. PMID: 28433569
- High VDBG concentration was associated with coronary heart disease events in all racial and ethnic groups. PMID: 28472285
- SNPs rs7041 and rs4588 of VDBP are not associated with the levels of 25-hydroxyvitamin D nor with the prevalence and extent of CAD. 25-hydroxyvitamin D levels but not VDBP genetic status independently predicted the occurrence of coronary lesions at angiography. PMID: 28779988
- Genetic variant in vitamin D-binding protein is associated with metabolic syndrome. PMID: 28278285
- Study suggests higher (versus lower) circulating DBP may be independently associated with a decreased prostate cancer risk in black men independent of 25(OH)D status. PMID: 28369777
- The data demonstrate a relationship between the diurnal rhythms of 1,25(OH)2D and DBP, possibly to maintain free 1,25(OH)2D concentrations. PMID: 28732681
- the interaction between 25(OH)D status and some maternal GC variants influence the birth weight of infants PMID: 28241988
- The results of this study suggest that DBP is not involved in the pathogenesis of MS in Italians. PMID: 28284354
- This report summerizes current understanding of vitamin D-binding protein, its genetic determinants, and their effect on calcifediol concentrations. (Review) PMID: 27742848
- Allelic variations in CYP2R1 and GC affect vitamin D levels, but variant alleles on VDR and DHCR7 were not correlated with vitamin D deficiency. PMID: 26038244
- Patients with primary hyperparathyroidism have lower serum VDBP than controls. PMID: 27682354
- VDBP polymorphism is associated with vitamin D deficiency. PMID: 27768857
- genome-wide association study in population of children/adolescents in Colorado: Data suggest that VDBP is an autoantigen in development of autoimmune type 1 diabetes (T1D) in the population studied; serum 25-hydroxyvitamin D levels are negatively correlated with VDBP-autoantibody levels in patients in whom T1D developed during the winter. [META-ANALYSIS] PMID: 26983959
- VDBP rs222020 C > T polymorphisms may be predisposition factors of adolescent idiopathic scoliosis and the efficacy of brace treatment. PMID: 27856225
- findings do not support a role of an independent effect of the investigated vitamin D-related gene variants, VDBP and CYP27B1, in the risk of Multiple Sclerosis PMID: 27904983
- The polymorphisms in the VDR and VDBP genes appeared to be responsible for host susceptibility to human tuberculosis in a Taiwanese population. PMID: 26869016
- No association was observed between GC or VDR polymorphisms and breast cancer risk. associations between vitamin D-related genetic variants and breast cancer were not observed overall, although the relationships between vitamin D pathway polymorphisms and breast cancer may be modified by menopausal status and breast tumour subtype PMID: 26631034
- In a Pakistani population, no statistically significant associations between SNPs in VDR, DBP, and CYP2R1 and tuberculosis was demonstrated. PMID: 27160686
顯示更多
收起更多
-
亞細胞定位:Secreted.
-
蛋白家族:ALB/AFP/VDB family
-
組織特異性:Expressed in the liver. Found in plasma, ascites, cerebrospinal fluid and urine.
-
數(shù)據(jù)庫鏈接:
Most popular with customers
-
YWHAB Recombinant Monoclonal Antibody
Applications: ELISA, WB, IHC, IF, FC
Species Reactivity: Human, Mouse, Rat
-
Phospho-YAP1 (S127) Recombinant Monoclonal Antibody
Applications: ELISA, WB, IHC
Species Reactivity: Human
-
-
-
-
-
-